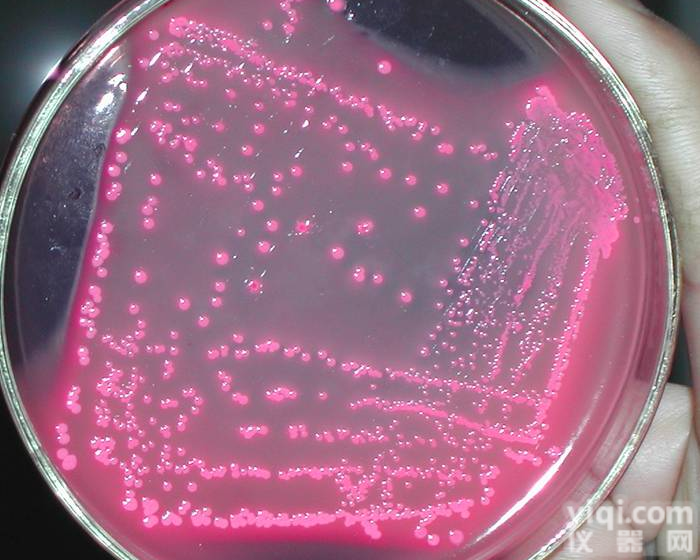
肠<em>球菌</em><em>琼脂</em>（<em>胆汁</em>七叶苷叠氮钠<em>琼脂</em>）

产品信息
肠球菌琼脂(胆汁七叶苷叠氮钠琼脂产品说明及用途
培养基(Medium)是供微生物、植物和动物组织生长和维持用的人工配制的养料,一般都含有培养基有碳水化合物、含氮物质、无机盐(包括微量元素)以及维生素和水等。有的培养基还含有KJ素和色素。
【一般贮存】必须防潮、避光、阴凉处保存
【组织培养基贮存】较长时间的贮存,必须放在2~6℃的冰箱内
【注意事项】:由于液体培养基不易长期保管,现在均改制成粉末。
肠球菌琼脂(胆汁七叶苷叠氮钠琼脂产品展示:
20708 头孢菌素纸片 30ug×20 片/瓶
20709 萘啶酮酸纸片 30ug×20 片/瓶
31001 动力-硝酸盐培养基(A 法) 10ml×20 支/箱
21208 动力-硝酸盐培养基(A 法) 2ml×10 支/盒
21111 明胶生化管 1ml×10 支/盒
20704 3.5%氯化钠试验 10ml×20 支/箱
20713 1%甘氨酸生长试验 10ml×20 支/箱
20714 半胱氨酸产硫化氢试验 10ml×20 支/箱
51701 去氧胆酸钠 0.05g×4 支/盒
21102 苯丙氨酸培养基 4ml×10 支/盒
31203 改良 V-P 培养基 5ml×20 支/箱
31002 缓冲动力-硝酸盐培养基 11ml×20 支/箱
31003 乳糖-明胶培养基 10ml×20 支/箱
30206 克氏双糖铁琼脂(KI)斜面(限供汽运) 10ml×20 支/箱
30214 营养琼脂斜面(限供汽运) 10ml×20 支/箱
30306 三糖铁(TSI)琼脂(限供汽运) 10ml×20 支/箱
30702 半固体储存培养基(限供汽运) 10ml×20 支/箱
30803 营养琼脂小斜面 4ml×10 支/盒
20202 氧化酶试纸 10 片/瓶
50702 氧化酶试剂 1g/瓶
31701 绿脓菌素测定用培养基(PDP)斜面(限供汽运) 10ml×20 支/箱
20214 变形杆菌套装生化鉴定管 12 种 14 支/套×10 套
86
"第五部分 其它产品"
1、微生物检验原材料
编号 产品名称 规格
50125 可溶性淀粉 250g/瓶
50126 麦芽浸粉 250g/瓶
50127 混合蛋白胨 250g/瓶
51001 细菌学蛋白胨 250g/瓶
50103 胰蛋白胨 250g/瓶
50104 胰酪蛋白胨 250g/瓶
50105 牛肉浸粉 250g/瓶
50106 植物蛋白胨 250g/瓶
50107 月示胨 250g/瓶
50108 多价蛋白胨 250g/瓶
50109 酸水解酪蛋白 250g/瓶
50110 牛肝浸粉 100g/瓶
50111 牛心浸粉 100g/瓶
50112 脑心浸粉 100g/瓶
50113 玉米浸粉 100g/瓶
50114 玉米淀粉 100g/瓶
50115 明胶蛋白胨 250g/瓶
50116 马铃薯淀粉 250g/瓶
50117 酵母浸粉(国产) 250g/瓶
50118 酵母浸粉 250g/瓶
51102 细菌学琼脂粉 250g/瓶
50120 3 号胆盐 100g/瓶
50121 去氧胆酸钠 100g/瓶
50122 牛胆盐 100g/瓶
50138 脱水牛胆粉 100g/瓶
50123 猪胆粉 100g/瓶
50124 十二烷基硫酸钠 100g/瓶
50128 血清消化粉 250g/瓶肠球菌琼脂(胆汁七叶苷叠氮钠琼脂